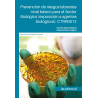
Prevención de riesgos laborales nivel básico para el Sector Biológico (exposición a agentes biológicos). CTRR0012

Producto añadido correctamente a su carrito de la compra
Cantidad
Total
Hay 0 artículos en su carrito. Hay 1 artículo en su cesta.
Total productos:
(impuestos inc.)
Total envío: (impuestos inc.)
A determinar
Impuestos
0,00 €
Total
(impuestos inc.)
Categorías
-
Capacitación profesional
- Administración y gestión
- Agraria
- Artes gráficas
- Comercio y marketing
- Derecho
- Desarrollo web - multimedia
- Diseño CAD
- Diseño gráfico
- Docencia - Pedagogía
- Edificación y obra civil
- Electricidad y electrónica
- Energía y agua
- Fabricación mecánica
- Formación complementaria
- Fotografía
- Habilidades directivas
- Hostelería y turismo
- Idiomas
- Imagen personal
- Industrias alimentarias
- Informática y comunicaciones
- Instalación y mantenimiento
- Medio ambiente
- Sanidad
- Seguridad
- Servicios socioculturales
- Social Media
- Tarjeta Profesional de la Construcción
- Transporte y mantenimiento de vehículos
- Veterinaria y cuidado de animales
-
Certificado de profesionalidad
- Actividades físicas y deportivas
- Administración y gestión
- Agraria
- Artes Gráficas
- Comercio y marketing
- Edificación y obra civil
- Electricidad y Electrónica
- Energía y agua
- Fabricación mecánica
- Hostelería y turismo
- Imagen personal
- Industrias alimentarias
- Industrias extractivas
- Informática y comunicaciones
- Instalación y mantenimiento
- Madera, mueble y corcho
- Química
- Sanidad
- Seguridad y medio ambiente
- Servicios socioculturales y a la comunidad
- Textil, confección y piel
- Transporte y mantenimiento de vehículos
-
Especialidades formativas
- Administración y gestión
- Agraria
- Artes gráficas
- Artes y artesanía
- Comercio y marketing
- Competencia Transversal
- EDIFICACIÓN Y OBRA CIVIL
- Electricidad y electrónica
- Energía y agua
- Fabricación mecánica
- Formación complementaria
- Hostelería y turismo
- Industrias alimentarias
- Informática y telecomunicaciones
- INSTALACIÓN Y MANTENIMIENTO
- Sanidad
- Seguridad y medio ambiente
- Servicios socioculturales
- Textil, confección y piel
- Transporte y mantenimiento de vehículos
Tus últimas consultas
-
Prevención de riesgos...
Autores: Vicente García Segura,...
¡Lo más vendido!
-

-

Operaciones auxiliares de almacenaje MF1325_1
Autor: Federico Serrano AlonsoPáginas: 330ISBN: 978-84-9198-692-8Fecha...
30,58 € -

Rescate de accidentados en instalaciones acuáticas MF0271_2 (2ª Ed.)
Autora: Rosario Olmedo JaraPáginas: 230ISBN: 978-84-9198-825-0Fecha...
21,11 €
Opiniones









